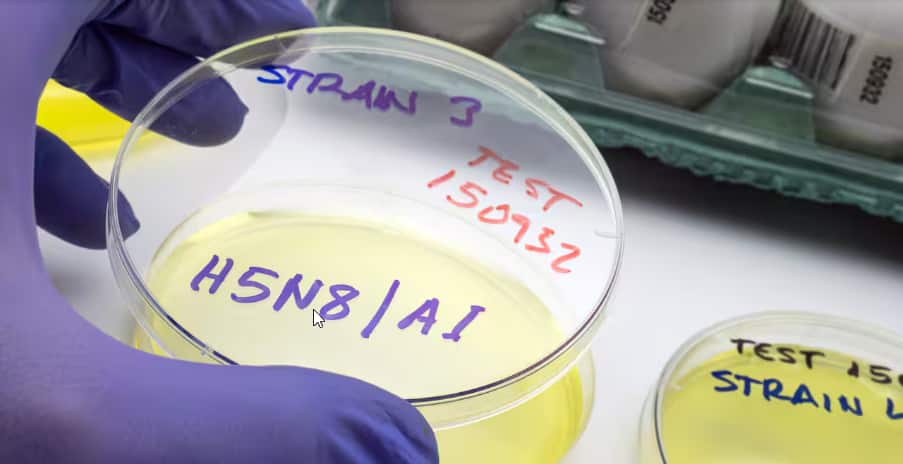
bird flu 2.png

Các nhà khoa học đã phát hiện ra, H5N5 ở động vật vào khoảng năm 2008.
Trường hợp đầu tiên nhiễm biến thể này ở người, được phát hiện tại Hoa Kỳ trong năm nay và người đàn ông này, vốn có bệnh lý nền, đã tử vong vào tháng 11.
Một trường hợp, không phản ánh đầy đủ nguy cơ mà biến thể này gây ra, nhưng Giáo sư Adrian Esterman, nhà dịch tễ học và thống kê sinh học tại Đại học Nam Úc cho biết, việc H5N1 có tỷ lệ tử vong ở người cao như vậy, khoảng 48%, đồng nghĩa với việc bất kỳ sự lây lan nào của các biến thể cúm gia cầm sang người, đều là "một mối lo ngại lớn".
Vào tháng 11, chính phủ liên bang đã xác nhận chủng H5N1, đã được phát hiện lần đầu tiên trên đảo Heard xa xôi, cách Perth 4.000km về phía tây nam và cách Nam Cực 1.700km về phía bắc.
Tuy nhiên con người mắc cúm gia cầm như thế nào?
Hầu hết các trường hợp cúm gia cầm gần đây, đều xảy ra ở Hoa Kỳ.
Giáo sư Esterman cho biết, cúm gia cầm đã lây truyền từ động vật sang người, thông qua tiếp xúc vật lý với vi-rút.
Mặc dù vi-rút này cũng có ở chim hoang dã, nhưng con người thường mắc bệnh từ chim nhà, hoặc từ gia súc và bò sữa.
"Thông thường đó là xác động vật chết, và bạn biết đấy, chúng sẽ chạm vào xác động vật chết, nhưng tôi cho rằng chúng có thể nhiễm virus chỉ từ phân trên mặt đất", Adrian Esterman.
Esterman cho biết, hầu hết những người nhiễm virus đều làm việc trong ngành công nghiệp sữa hoặc gia cầm, hoặc có liên quan đến những ngành này.
Ông nói rằng, mặc dù virus có thể lây truyền từ người sang người, nhưng có rất ít hoặc không có bằng chứng nào cho thấy, nó lây lan theo cách này.
Sau ca tử vong đầu tiên do chủng cúm gia cầm H5N5, các chuyên gia cảnh báo loại virus này, với một số chủng đang lưu hành ở nhiều nơi trên thế giới, có thể dẫn đến đại dịch tiếp theo trên thế giới.
Ca tử vong này cũng xảy ra khi cúm gia cầm lần đầu tiên, được phát hiện tại một vùng lãnh thổ bên ngoài Úc.
Các cơ quan y tế châu Âu đã cảnh báo trong tháng này rằng, các chính phủ nên tăng cường nỗ lực chống lại các mối đe dọa của cúm gia cầm, trong bối cảnh số lượng các đợt bùng phát "chưa từng có" vào mùa thu ở Bắc bán cầu.
Kể từ tháng 9, hơn 1.400 ca nhiễm ở chim hoang dã và gia cầm đã được phát hiện tại ít nhất 26 quốc gia châu Âu, cao gấp bốn lần so với một năm trước và là mức cao nhất kể từ năm 2016, làm tăng nguy cơ virus có thể lây lan sang người, theo Trung tâm Phòng ngừa và Kiểm soát Dịch bệnh Châu Âu (ECDC).
Các chuyên gia cho biết khả năng virus này trở thành đại dịch tiếp theo đang ngày càng cao, điều này rất đáng lo ngại vì tỷ lệ tử vong cao hơn COVID-19.
Thế nhưng chúng ta biết gì về mầm bệnh cúm gia cầm?
Giáo sư Adrian Esterman, nhà dịch tễ học và thống kê sinh học tại Đại học Nam Úc cho biết, H5N5 giống như chủng loại đầu tiên được phát hiện ở người tại Hồng Kông vào năm 1997, H5N1, có khả năng lây nhiễm cao, ông nói với SBS News.
"Loại virus thực sự gây lo ngại hiện nay là H5N1, đang lây lan khắp thế giới, không chỉ giết chết hàng triệu loài chim hoang dã và chim nhà, mà còn ảnh hưởng đến các loài động vật có vú trên toàn thế giới. Đây đều là những gì chúng ta gọi là cúm gia cầm độc lực cao. Về căn bản, có hai loại cúm gia cầm: cúm gia cầm, loại khá nhẹ và về căn bản không giết chết chim hoang dã, được gọi là cúm gia cầm độc lực thấp, loại thứ hai là cúm gia cầm độc lực cao và cả H5N5 và H5N1, đều có độc lực cao”, Adrian Esterman.
Kể từ những ca lây truyền từ người sang người đầu tiên ở Hồng Kông, đã có hơn một chục chủng virus, với các ca bệnh bùng phát ở nhiều nơi khác nhau trên thế giới, vào những thời điểm khác nhau.
Có gần 1.000 trường hợp được ghi nhận, nhiễm chủng H5 từ người sang người, với ít nhất 476 ca tử vong được ghi nhận kể từ năm 2003.
Trung tâm Kiểm soát và Phòng ngừa Dịch bệnh Hoa Kỳ đã ghi nhận, có 11 ca tử vong do cúm gia cầm từ tháng 1 đến tháng 8, những ca này xảy ra ở Campuchia, Ấn Độ và Mexico.
Điều quan trọng là cúm gia cầm là một loại virus biến đổi, Giáo sư Esterman cho biết giống như virus corona, virus cúm gia cầm tiếp tục biến đổi.
"Chữ H và chữ N, là viết tắt của các protein tăng đột biến từ virus cúm. Điều xảy ra là, mỗi năm chúng có xu hướng thay đổi một chút, và cứ vài năm lại có một sự thay đổi lớn”, Adrian Esterman.
Được biết các đợt bùng phát của các chủng khác, bao gồm cả phân nhóm H7, đã xảy ra tại các trang trại gia cầm ở một số tiểu bang miền Đông, trong những năm gần đây và đã được loại trừ.
Còn Giáo sư Paul Griffin, bác sĩ chuyên khoa bệnh truyền nhiễm tại trường y của Đại học Queensland, cho biết cúm gia cầm có thể dẫn đến nhiễm trùng ngực, ho, khó thở và thậm chí suy hô hấp.
Như vậy cúm gia cầm có thể xâm nhập vào Úc không?
Cassandra Berry, giáo sư miễn dịch học tại Đại học Murdoch cho biết, các biến thể H5 của cúm gia cầm cuối cùng xâm nhập vào Úc, là điều không thể tránh khỏi.
"Chúng ta hiện đang bị virus bao vây. Úc và Nam Cực là những lục địa duy nhất trên thế giới không có dịch cúm gia cầm, nhưng điều đó đã thay đổi vài năm trước, khi các đợt bùng phát virus được ghi nhận ở Nam Cực và các đảo xung quanh. Ngay cả những người dẫn đầu đoàn thám hiểm, trong chuyến đi gần đây của tôi đến bán đảo Nam Cực hồi đầu năm nay, cũng nhận xét về việc xuất hiện ít hải cẩu ăn cua và chim cướp biển, có khả năng bị tiêu diệt, bởi một chủng cúm gia cầm độc lực cao”, Cassandra Berry.
Giáo sư Berry cho biết, nếu virus lây lan sang các loài động vật ở Úc, thì việc tiêu hủy và tiêm vắc-xin vòng, trong đó các quần thể động vật xung quanh các trường hợp được xác nhận, đã được tiêm vắc-xin, sẽ là biện pháp kiểm soát ưu tiên.
"Tuy nhiên, các nước láng giềng đã tiêm vắc-xin hàng loạt cho gia cầm của họ, để bảo vệ đàn gia cầm, ngành công nghiệp và nguồn cung cấp thực phẩm. Trong khi đó, giám sát virus là biện pháp an toàn sinh học quan trọng”, Cassandra Berry.
Thế nhưng có khả năng là có đại dịch tiếp theo hay không?
Cả ba giáo sư Berry, Griffin và Esterman đều đồng ý rằng, cúm gia cầm có khả năng trở thành đại dịch.
Giáo sư Berry nói.
"Một đại dịch luôn nằm trong tầm ngắm”, Cassandra Berry.
Còn giáo sư Esterman cho biết, một lý do khiến các chủng H5 gây ra nguy cơ lớn cho con người, là vì "nó có tỷ lệ tử vong rất cao.
"Tất cả những người đã nhiễm chủng H5N1 trong 20 năm qua, một nửa trong số họ đã tử vong, thật kinh khủng", Adrian Esterman.
Tỷ lệ tử vong do H5N1 là khoảng 48%, cao hơn nhiều so với tỷ lệ tử vong gần 3%, của COVID-19.
Còn giáo sư Griffin cho biết, mặc dù có rất nhiều biến số cần xem xét, nhưng nếu cúm gia cầm bắt đầu lây lan từ người sang người, ông ước tính chỉ mất vài ngày để "thực sự lan rộng khắp thế giới".
Ông nói rằng việc "chúng ta không thấy nhiều ca nhiễm ở người, và hiện tại rất hiếm khi thấy sự lây lan từ người sang người", là một điều đáng an tâm.
Tuy nhiên ông cho biết, ngày càng nhiều loài chim và các loài động vật khác bị ảnh hưởng và virus đang lan rộng về mặt địa lý.
"Vì vậy, tình hình có khả năng trở nên nghiêm trọng, nếu khả năng lây truyền sang người, và giữa người với người tăng lên", Paul Griffin.
Ông cho biết, việc theo dõi quần thể động vật là rất quan trọng.
"Chúng ta cần theo dõi những thay đổi tiềm ẩn, có thể khiến các loại cúm này dễ lây truyền hơn ở người, và chúng ta cần bảo đảm rằng việc giám sát được tiếp tục, đồng thời chúng ta cũng phải chuẩn bị cho trường hợp nó lây nhiễm sang người, về cách chúng ta sẽ ứng phó với điều đó", Paul Griffin.
Ông cho biết mặc dù đã có vắc-xin phòng ngừa H5N1, nhưng hiện tại vẫn chưa có vắc-xin phòng ngừa H5N5.
"Với công nghệ vắc-xin rộng hơn, chúng ta đang ở vị thế thuận lợi khi có thể điều chỉnh vắc-xin nhanh hơn, nhưng vắc-xin cúm và nền tảng truyền thống, cần khá nhiều thời gian để sản xuất”, Paul Griffin.
Được biết trước sự bùng phát của cúm gia cầm vào tháng 10 năm 2024, Chính phủ đã cam kết thêm 95 triệu đô la, để bảo vệ Úc và chuẩn bị cho đất nước.
Khoản tài trợ này được sử dụng, để tăng cường năng lực ứng phó an ninh sinh học quốc gia, giám sát và chuẩn bị y tế công cộng.
READ MORE

SBS Việt ngữ
Đồng hành cùng chúng tôi tại SBS Vietnamese Facebook và cập nhật tin tức ở sbs.com.au/vietnamese
Nghe SBS Tiếng Việt trên ứng dụng miễn phí SBS Audio, tải về từ App Store hay Google Play







